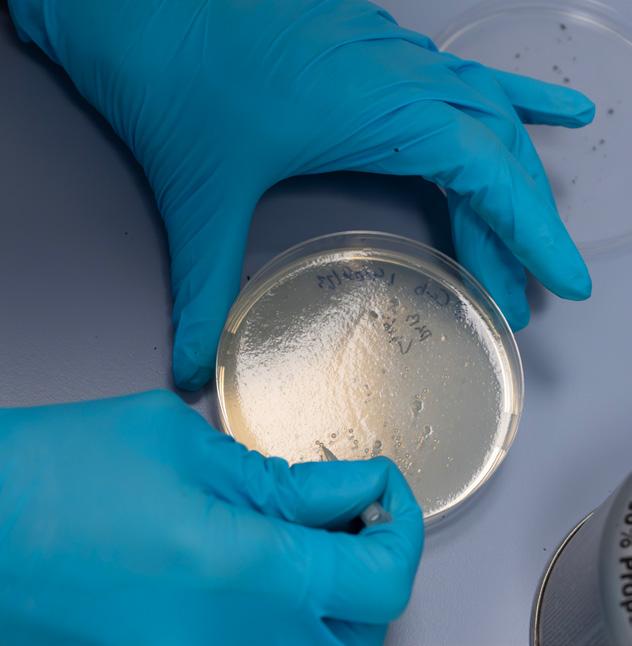

![]()












Thanks to your support, we’ve had a fantastic 2024 so far. Our financial year ending in June 2024 was remarkable – more than £8.6 million was raised to help find a cure for brain tumours. We granted a record £3.4 million to fund research at our Brain Tumour Research Centres of Excellence, as well as to support important initiatives in collaboration with other organisations. Our campaigning took us to the door of Number 10 Downing Street as we handed in our petition which was signed by more than 81,000 of you and the then Health Minister attended our manifesto launch event at Westminster.
You also helped us mark our biggest ever Brain Tumour Awareness Month and many of you shared your stories to raise the profile of this devastating disease. Together, we lit up the UK and we celebrated Wear A Hat Day by wearing our best headgear and raising hundreds of thousands of pounds.
As the leading voice of the brain tumour community in the UK, we’re increasing the number of highprofile people who engage with our cause and we’re proud to welcome our new Patron, Alfie Boe OBE, to our family. Alfie lost his dad to a brain tumour, and you can read more about his passion for our cause on pages 22-23 of this magazine.
The funds and awareness you have raised have enabled us to make some really exciting research progress and you’ll also read about a bumper crop of discoveries which could get us closer to a cure. They include the launch of a new clinical trial, a world-first blood test to help diagnose brain tumours, and a discovery which could lead to much-needed personalised treatments.




We have hugely exciting plans on the horizon and we’re particularly proud to share that we are partnering with Beatson Cancer Charity with the ambition to launch the Scottish Brain Tumour Research Centre of Excellence in 2025. The Centre, situated in the universities of Edinburgh and Glasgow, will represent a significant investment in Scotland and complement our other Centres of Excellence at the University of Plymouth, Imperial College London, Queen Mary University of London, and the Institute of Cancer Research, London.
To achieve our ambition of opening our fifth Research Centre, while continuing to fund our existing network of Centres and driving forward with our campaigning, we need your help. Inside this magazine you’ll find a myriad of ways you can get involved, including the return of our popular Walk of Hope on Saturday 28th September.

You can also visit our website to find more ways you can help find a cure: www.braintumourresearch.org/ pages/help-find-a-cure

Below: The Brain Tumour Research team on Wear A Hat Day

Our Trustees play a key role in the development of the Charity. This year has also seen our Board of Trustees undergo a number of changes. From 1st July, Wendy Fulcher stood down as Chair of Brain Tumour Research. The role of Chair has now been taken up by Rob Hughes (formerly Deputy Chair) and Sue Farrington Smith MBE, Trustee and founding Chief Executive of the Charity, has become Deputy Chair. I would like to extend a huge thanks to Wendy for her invaluable service as Chair and her continued support as a Trustee. I know we will be in very capable hands with Rob at the helm and Sue alongside.
And of course, I must extend my most heartfelt thanks to you – our loyal supporters. Without your dedicated commitment and passion for our cause, we could not continue to fund the fight against brain tumours. So, as we enter this new and exciting period, please stay with us and continue to support Brain Tumour Research in any way that you can.
Together we will find a cure

Dan Knowles CEO

We are proud to announce a unique collaboration with Beatson Cancer Charity to change the story for brain tumour patients in Scotland. Our two leading charities are joining forces in a powerful new alliance which will focus on finding a cure for the deadly brain cancer, glioblastoma (GBM).
Our ambitious plans would see the creation of the largest group of multidisciplinary GBM researchers in the UK working to bridge the gap between promising new discoveries and patient benefit, from the research laboratory to the hospital bedside.



We’re bringing together our 15 years of experience changing the landscape for the brain tumour community in the UK, with Beatson’s strong track record working in the heart of communities and in hospitals to transform the way cancer care is funded and delivered in Scotland.
If we can secure the funding needed, this collaboration will see the opening of the Scottish Brain Tumour Research Centre of Excellence, working across the world-class facilities of the universities of Edinburgh and Glasgow with leading experts in the field targeted to bring forward desperately needed clinical trials for GBM, the most commonly diagnosed high-grade brain tumour in adults.
Our CEO, Dan Knowles, said: “New, improved treatments for GBM patients are desperately needed. At present, new discoveries and approaches are not progressing quickly enough into clinical testing in patients. The proposed Scottish Brain Tumour Research Centre of Excellence will help bridge this gap, leading to pivotal preclinical proof-of-concept data to support clinical trial development for patients. The Centre represents a significant investment in Scotland and will complement our other Centres of Excellence at the University of Plymouth, Imperial College London, Queen Mary University of London and the Institute of Cancer Research.”

The collaboration has been welcomed by many patients and families affected by GBM. Our Patron, Theo Burrell, was diagnosed with the disease in June 2022 and has undergone extensive treatment.
She said: “This announcement is great news for brain tumour patients like me in Scotland. Although I continue to make the best of each day, my tumour will return, and it will kill me. My care has been excellent and new advances in science have helped me so far. However, only by funding research into brain cancer can we get closer to a life-saving cure.”



Her thoughts were echoed by Claire Cordiner, from Edinburgh, whose mum, Margaret O’Kane, youngest sister Angie Jones, and 18-year-old nephew Max Jones all died from GBM.
“To know there might be a Scottish Brain Tumour Research Centre of Excellence is just fantastic news. Nobody knows why this is happening to our family and others over and over again. There are no answers because nobody knows why, so it’s vital we get the funding for this research to happen and for breakthroughs to be made,” Claire said.
“Brain tumours are the biggest cancer killer of children and adults under 40, but they don’t receive the funding they should. People need to be aware of how much this devastates families and the funding needs to be there to investigate this devastating illness. To hear there are developments coming out of the Scottish Centre would be incredible. It would mean so much to me and my family.”
To find out more about our ambitions in Scotland, and how you can help, visit: www.braintumourresearch.org/ pages/changing-thestory-for-scotland
The Brain Tumour Research Centre of Excellence at the University of Plymouth is making great progress in its work to improve the diagnosis and treatment of low-grade brain tumours.

Among the exciting recent developments is a study which has furthered our understanding of how glioma tumours develop. Using the fruit fly model, drosophila, Dr Claudia Barros and her team uncovered the “readying” process which occurs in cells just prior to brain tumour onset which could be vital for tumour growth. This discovery opens new avenues of research to find potential new therapies for glioma patients.
Early-stage research holds the key to finding new treatments and cures, and a study conducted by Dr Juri Na, working with Professor Oliver Hanemann at our Plymouth Centre, has revealed more about what causes meningiomas – the most commonly diagnosed primary brain tumour in adults – to become resistant to radiotherapy.
Dr Na found that an enzyme called HDAC6 was significantly increased in meningioma cells which had undergone radiotherapy. In her research, she pretreated meningioma cells with a chemical called CAY10603 to block the effect of HDAC6 and found that it made radiotherapy more effective in lab models


and resulted in tumours shrinking. Although in its very early stages, this could help us find new ways to make radiotherapy more effective and improve outcomes for patients diagnosed with high-grade meningioma and those whose tumour cannot be surgically removed due to its location.
Crucially, the Plymouth team’s work to translate their research into clinical benefits for patients took a significant step forward. They launched a year-long clinical trial to see whether anti-retroviral drugs could be used to treat people with Neurofibromatosis 2 (NF2) – a rare inherited genetic condition which causes tumours such as schwannoma (which include acoustic neuroma), ependymoma and meningioma.
The RETREAT clinical trial, led by Professor Oliver Hanemann and funded by the Children’s Tumor Foundation, will expand on research which showed the repurposed drugs reduced tumour growth and survival in the tumours. If successful, it could progress to a larger trial and bring about significant change for patients affected by NF2, for which there is currently no effective treatment.
The most commonly diagnosed high-grade brain tumour in adults, glioblastoma (GBM) affects around 3,200 adults in the UK every year. Treatments have remained unchanged for 20 years, but recent breakthroughs from the Brain Tumour Research Centre of Excellence at Imperial College London bring much-needed hope.
In what is thought to be a world first, the simple blood test, TriNetra-Glio, could be used to diagnose glial tumours by identifying tumour cells that have broken free from the tumour and are circulating in the blood.
It could mean patients with suspected high-grade gliomas, including GBM, receive quicker confirmation of the presence of a glioma tumour and therefore are able to access the treatment they need faster. The blood test could also eliminate the need for surgical biopsies, which carry significant risk, to diagnose these tumours.
As well as working to improve the diagnosis of high-grade brain tumours, the team at Imperial is working to advance treatments and in another exciting development they have discovered a way to improve the effectiveness of the chemotherapy drug, Temozolomide (TMZ), and radiotherapy.
Cancer cells require high levels of energy to maintain their rapid growth and a key component of this is a chemical called NAD. Blocking NAD production in cancer cells has been explored as a potential treatment, but this has so far proven ineffective as a standalone therapy.
New research, led by Dr Richard Perryman, who began the work as part of his PhD project and continued as
To receive all the latest research updates and more straight to your inbox, subscribe to receive our weekly e-news: www.braintumourresearch.org/subscribe
a post-doc at the Centre, found that blocking NAD production using a drug called FK866 in combination with radiotherapy or TMZ, makes the treatment more effective for an easily identifiable subgroup of GBM patients. This breakthrough brings us one step closer to grouping patients according to their response to treatment, and thus personalised treatment options for GBM patients.

An important breakthrough from the Brain Tumour Research Centre of Excellence at Queen Mary University of London has furthered our understanding of glioblastoma (GBM) and could pave the way to new treatments for this devastating tumour type.
With just 25% of people diagnosed with GBM surviving for more than a year, new treatments are urgently needed for this devastating tumour type. Currently there are very limited treatment options for these complex tumours. The work taking place at the Brain Tumour Research Centre of Excellence at Queen Mary University of London is making positive steps towards our vision of finding a cure and, crucially, improving treatment options for patients.
Dr Myrianni Constantinou in the lab
A recent breakthrough from the Centre has furthered our understanding of GBM, revealing that a gene known as METTL7B is essential in regulating the growth of GBM tumours. It’s exciting because it could pave the way to new treatments.
Dr Myrianni Constantinou, a Brain Tumour Researchfunded scientist, found that the gene is overactive in GBM tumours but when the gene was silenced, the resultant tumours were significantly smaller. The tumour cells however travelled more into the surrounding areas of the brain making the tumour more invasive.

Brain tumours kill more children and adults under the age of 40 than any other cancer
Creating a network of seven sustainable Centres of Excellence across the UK to find a cure
Although in its very early stages, the research could provide researchers with new insights into how to treat these tumours. Professor Silvia Marino, Director of our Centre at Queen Mary, explains: “The METTL7B gene has already been found to be overactive in a number of cancers, including low-grade glioma where it is associated with a poorer prognosis for patients. This new research is significant because it has increased our understanding of how GBM tumours grow and behave and could provide researchers with a new way of treating these tumours.
“It has opened the way for research into a new potential combination therapy, using two types of drug; one to slow tumour growth and one to target invasiveness, which may result in smaller, less aggressive tumours.”

Dr Karen Noble, our Director of Research, Policy and Innovation, said: “Treatments for GBM haven’t changed in decades so the work being done by the team at Queen Mary brings much-needed hope of new options for patients in the future. We thank all of our supporters whose dedicated fundraising and awareness-raising enables us to fund this vital research.”
Your support makes these important research breakthroughs possible. Visit our website to set up a regular donation or give a one-off amount: www.braintumourresearch.org/donate



Saturday 28th
Mark this year’s walk in your diary!






Since its humble beginnings as a canal-side stroll, Walk of Hope has grown into one of our most popular events. Thousands of people across the UK get involved by wearing our pink t-shirts and stepping out with their loved ones to raise money and awareness for Brain Tumour Research.
Our step-tacular fundraiser takes place this year on Saturday 28th September. Will you step forward with us to help find a cure for brain tumours?
Brain Tumour Research Walk of Hope events are taking place in:
•Paddington Recreation Ground in London
•Strathclyde Country Park in Motherwell
•Torpoint in Cornwall
•Chatsworth House in Derbyshire
•Ellesmere in Shropshire
•Wardown Park in Luton
There’ll be food and drink, entertainment and, of course, a great route at each. Sign up and you’ll walk alongside hundreds of like-minded supporters all with one common goal: to find a cure for brain tumours.
Can’t join one of our events? Hold your own Walk of Hope wherever you are!
You can make your walk as easy or as challenging as you like. Team up with your family, friends, or colleagues and get as many people to join you as you can to make your event as big as possible.
Clare Smerdon was a new mum to her son Teddy when she was diagnosed with a glioblastoma (GBM). Last September, shortly after she finished treatment, she took part in our Walk of Hope and now, she’s planning her own event. “A lot of people diagnosed with

brain tumours think why fight?
But I can go along, do this simple thing, and raise funds and awareness so that in years to come, when a cure is found, I’ll know I’ve done my bit,” she said.

Michelle Collins is also planning her own walk and will be joined by pals along the Leeds to Liverpool canal. It’s after she had to relearn how to walk following surgery to remove a meningioma in 2020.
She said: “I count myself as one of the lucky ones because my tumour was low-grade. I know I’ll never fully recover, but I can still live a relatively normal life. I was shocked to find out how little funding goes into researching this disease so I decided I’d do a Walk of Hope to raise money so that we can learn more about brain tumours and hopefully find new treatments and cures in the future.”
Whether you join one of our events or hold your own, please get involved and help raise vital funds and awareness to find a cure for brain tumours.
Register NOW to access your downloadable fundraising pack: www.walk-of-hope.org

Can you help keep our vital research going by leaving a gift in your will, knowing that your legacy will be improving outcomes for brain tumour patients and will help to find a cure? With each day of research costing £2,740, your gift could make a big difference. Whether large or small, it will help to transform the future of research into brain tumours and bring hope to the thousands diagnosed and living with this devastating disease.
Brain Tumour Research is the only national charity in the UK dedicated to raising funds for continuous and sustainable scientific research into brain tumours. And we are the leading voice of the UK brain tumour community, calling for greater support and action for research into what scientists are calling the last battleground against cancer.
It doesn’t need to cost you a penny to get your will written – and charitable legacies are exempt from tax. Many people use gifts to charities as a way of lowering the inheritance tax levied on their estate or of avoiding the tax altogether.
We are partnered with Octopus Legacy (which covers the whole of the UK, including the Channel Islands) and the National Free Wills Network (covering England and Wales only) so you can have a simple will written or updated for free. There is no obligation to leave a gift to Brain Tumour Research when using this service – although we would be extremely grateful if you did.
Brain tumours are indiscriminate; they can affect anyone at any age
to continue to fund life-saving research HELP US SCAN HERE FOR MORE
For more information about leaving a gift in your will to Brain Tumour Research, or even considering doing so, email: legacy@braintumourresearch.org


A donation in memory of father-of-three
Sam Bravo-Hibberd is funding 100 days of vital research in the hope that families affected by brain tumours in the future will have more time together.
This generous gesture was made by his wife, Mauricee, following Sam’s death just five months after diagnosis, aged 35, on 4th February 2024.


A year of confusion and personality changes, followed by headaches, led to the discovery of Sam’s glioblastoma (GBM) two months after the birth of their third child, in September 2023.

He underwent surgery and radiotherapy, and the family launched an appeal to raise money for private treatment but, tragically, Sam died soon after it began.
Determined to ensure her husband’s legacy lives on, Mauricee’s donation is sponsoring 100 days of next generation genome sequencing at our Research Centre of Excellence at Queen Mary University of London.

Sam’s legacy gives hope to other families

She said: “Sam passed away still waiting for his whole genome sequencing to come back which they were hoping would open more treatment options. The research being carried out in his name aims to deliver more effective treatment and a better prognosis for other brain tumour patients and allow them more time with their loved ones.”
Mauricee will visit each of our Centres of Excellence to place tiles on the Wall of Hope and a host of exciting fundraising events are in the pipeline, following a charity football match that was held to mark Sam’s 35th birthday on 19th June.
Our thanks to Mauricee for her continued support.
You can help to make a difference and bring hope to families affected by brain tumours by making a donation, however big or small: www.braintumourresearch.org/donate

Andy took on fundraising50 challenges
Whether it’s putting in the miles for an endurancetesting challenge or cooking up a storm for a brilliant bake sale and much more besides, our supporters constantly amaze us with the inventive and ingenious ways they raise funds for Brain Tumour Research.
Here are just a few of their incredible stories to inspire you.
When Andy Stammers was diagnosed with a grade 3 astrocytoma, he was given just two years to live. But a decade after his diagnosis, Andy celebrated a milestone 50th birthday he never thought he’d see. To mark the special occasion, Andy embarked on a series of 50 fundraising challenges which raised more than £3,000 for us and saw him complete some unique activities, including reciting 50 lines in a local theatre production and folding 50 origami llamas.
Sometimes a challenge can hit all the right notes and brain tumour patient, David Aird, and teenager, Alfie Beston, both put their musical talents to the test with their fundraising endeavours. Rock musician David was diagnosed with a meningioma in 2017 and decided to donate half the proceeds of his limited-edition album, Still Got A Sense Of Tumour, to us. To buy the album, visit: www.sixstringsandapulse.bandcamp.com

Alfie plays the organ


Meanwhile, Alfie collaborated with more than 40 musicians on a reimagining of Bach’s famous Toccata and Fugue in D minor
The 17-year-old wrote a new arrangement of the piece before embarking on a two-year project to record, film and arrange the track into an incredible video which he released and raised more than £4,300
Georgina with some of her ballet dancers
In a touching tribute, dance teacher Georgina Parkinson marked what would have been her uncle Guy Dearden’s 68th birthday by teaching ballet classes using only songs the renowned pianist produced. Instead of charging for classes, she encouraged people to donate to Brain Tumour Research and raised more than £1,000






Having never done a cycling challenge, Ahi Anpananthar took it from zero to 100 as he and a group of pals completed the Ford RideLondon Essex 100-mile cycle. They raised more than £6,400 inspired by Ahi’s brother-in-law and our Supporter Ambassador, Sam Suriakumar, who is living with a glioma.
Footie fan Alex Schweitzer-Thompson turned his trip to see his national team play at the European Championships into a fundraising adventure in honour of his dad, Alan, who died of a glioblastoma (GBM). Alex and a dozen friends cycled 327 miles from Edinburgh to join the Tartan Army in Cologne to watch Scotland’s clash with Switzerland. Although Scotland’s Euros journey came to an unfortunate early end, Alex scored a blinder with his challenge, raising more than £10,000!

And finally, there was a blooming good turnout for green-fingered fundraiser Jill Maidment’s summer garden party, with tea, cake, garden games and a bumper raffle. Her community rallied round to help Jill raise more than £1,000 in memory of her husband Patrick, who died of an astrocytoma in 2017.


Patrick and his family

There really is no limit to the way you can fundraise for us and every pound you raise adds up to support our important research and campaigning. To find out more and let us know about your plans, visit our website:
www.braintumourresearch.org/fundraise/get-fundraising

Our supporters were putting in some medalworthy performances this summer as they took on epic challenges for Brain Tumour Research
A team of 82 runners took to the streets of London on Sunday 21st April and conquered the iconic TCS London Marathon. Together they raised an incredible total of more than £370,000 to help find a cure for this devastating disease – that’s enough to sponsor 135 days of research at a Brain Tumour Research Centre of Excellence.
Among them were pals Sam Boulting and Laura Thompson who completed their first marathon inspired by Simon Penwright, who died of a glioblastoma (GBM) last year. Laura wore one of our pink plush hats for the race, adorned with ribbons bearing the names of lost loved ones. The pair’s efforts have helped to top the total raised by Team Penwright so far to nearly £50,000






Greg Priddy also went all out for the race, dying his beard pink to match his Research running vest. He was diagnosed with a primary brain CNS lymphoma (PCNSL) in 2020.


Greg’s marathon was inspired by his son, William, who completed a virtual marathon whilst the family was shielding during the COVID-19 pandemic.
He said: “Getting a brain tumour diagnosis gives you a different perspective on life. You look at opportunities like this and realise you’ve got to take them because you don’t know if you’ll get them again or if you’ll be around to make the most of them next time.”







Running isn’t for everyone – some people prefer to take a leap of faith to fundraise for their favourite charity. Jill Blakemore braved a 10,000ft skydive on Saturday 8th June in memory of her “wonderful husband and best friend” Chris, who died from a GBM in March 2018.
Pensioner Bill Corner also took to the skies to fundraise for us. The 76-year-old lost his wife Sue to a GBM in 2020 and has raised thousands in her memory to help find a cure for the disease. “I know Sue would be proud of everything I have done in her honour so that we are closer to finding a cure for all types of brain tumours,” he said.
Twelve-year-old Leah Martin was the inspiration behind her family’s adrenaline-fuelled adventure. Her sister, Jasmine, and dad, Wayne, took on a 110ft freefall abseil from the Meldon Viaduct in Okehampton. Their bold efforts raised more than £1,000.
Jasmine said: “What an incredible experience! Brain Tumour Research is a charity very close to my heart and although my sister Leah may be ‘cured’, she still faces many struggles and proves that she’s 10 times braver than I ever will be on a daily basis.”

And these are just some of those who have faced their fears to support us. Thank you to everyone who signs up to do something amazing for Brain Tumour Research.

Raising more than £1,000

Feeling inspired to find your next fundraising adventure? Check out our calendar of upcoming challenges and register for your favourites online: www.braintumourresearch.org/ collections/events



Sat 7 th Tough Mudder Birmingham
Sun 8 th Great North Run


Conquer 20 obstacles and get seriously muddy

The world’s biggest half marathon with a fly-past from the Red Arrows
Sun 8 th Zipslide the Clyde A 100ft high adrenaline adventure
Sat 21st Tough Mudder South London Gear up for the ultimate challenge
Sat 28th Walk of Hope
Step forward to help find a cure: www.walk-of-hope.org
Sun 29 th Torbay Half Marathon and 10k Run along Devon’s spectacular coastline
Sun 29 th Robin Hood Marathon
Join us at Nottingham’s largest charity event
Sun 13th Oxford Half Marathon A fast and flat half marathon – perfect for setting a new PB
Sat 19th AJ Bell Great South Run
Sun 27 th Dublin Marathon
Sea air and glorious views are guaranteed on this 10-miler
Join 20,000 runners in the heart of Ireland’s capital NOVEMBER
All month Christmas cards and more
All month New challenge
Sat 16th-Sun 17 th Alton Towers Run


Buy our cards and merchandise ready for the big day
Follow us on Facebook to be amongst the first to hear
Choose from the 5k, 10k or half marathon and enjoy free ride access too DECEMBER
All month Christmas Appeal
Sat 7 th Santa in the City




Subscribe to our e-news for more: www.braintumourresearch.org/subscribe

Don your Santa suit for this festive run around Tunbridge Wells
Sign up for your favourite(s) on our website and keep an eye out as new challenges are added regularly www.braintumourresearch.org/ collections/events ...OR SCAN



Or do your own thing and fundraise your way for Brain Tumour Research: www.braintumourresearch.org/ fundraise/get-fundraising


JANUARY Event
Details
All month Fundraise your way Decide what you’ll do to help find a cure
All month Corporate Partnerships Nominate us to be your workplace’s charity of the year
FEBRUARY

All month 10,000 Steps a Day Back for a fifth year, will you step up to the challenge?
MARCH
All month Brain Tumour Awareness Month Help us raise awareness as we mark this annual campaign
Sun 2nd Brighton Half Marathon Thousands of cheering supporters make this a great event
Thur 27 th Trek Sahara An unforgettable six-day trek across the Moroccan Sahara
Fri 28th Wear A Hat Day Get involved in our flagship fundraiser and put your hats on for hope
APRIL

Sun 6th London Landmarks Half Marathon See the sights as you run this route like no other
Sun 27 th TCS London Marathon Did you get a place in the ballot? Run for research!
Sun 27 th adidas Manchester Marathon Join our team at the UK’s second largest marathon
MAY

All month 200k in May Challenge Join our team and complete an epic chellenge your way
Sat 3rd-Sun 4th Isle of Wight Ultra Challenge Head to the stunning island for this epic challenge
Sun 4th MK Marathon Head to the home of Brain Tumour Research for this popular event
Sun 11th Rob Burrow Leeds Marathon Enjoy the support of thousands of spectators at this brilliant event



Sat 17 th-Sun 18th Jurassic Coast Ultra Challege Walk, jog or run along the spectacular coastline Sun 18th Hackney Half Experience the vibrant atmosphere and community spirit
Sun 18th AJ Bell Great Manchester Run Race 10k or a half marathon through the buzzing Mancunian streets
Sat 24th-Sun 25th London 2 Brighton Ultra Challenge Travel from capital to coast on this 100km challenge (other distances available)
JUNE
Sat 7 th-Sun 8th Lake District Ultra Challenge Take on some of the UK’s finest countryside at your pace
Sat 28th-Sun 29th Peak District Ultra Challenge Join more than 2,000 challengers in idyllic Bakewell
JULY
Sat 26th North Downs 50 Ultra Challenge A looped 50km route taking in the North Downs Way
AUGUST
All month Cycle 274 Miles Our summer cycling challenge returns by popular demand
Sat 2nd South West Coast 50 Ultra Challenge Choose from the 50km, 25km or family-friendly 10km distances



BLOOMS FOR A GOOD CAUSE Alfie’s rose is available to preorder now – from £19.99 Search “Alfred Robert Boe” at www.roses.co.uk

We are thrilled to welcome global singing sensation, Alfie Boe OBE, as our newest Patron who is working tirelessly to raise awareness of the vital work we do.
The multi-platinum-selling recording artist and West End and Broadway star was announced as the latest high-profile supporter to join the Brain Tumour Research family in May. Alfie knows only too well the devastation that this disease can cause, since he was just 23 when he lost his father, Alfred, to a brain tumour in 1997. Like so many of you, Alfie bravely shared his father’s story with us, which you can read on our website.
Alfie, who supported our and Wear A Hat campaigns during Brain Tumour Awareness Month in
“I feel very proud to be a Patron of Brain Tumour Research, but it makes me angry that, in all this time, the situation for patients like Dad hasn’t really
changed. I feel incredibly sad to think that families are still facing this awful diagnosis and, nearly 30 years later, there have been so few advances in treatment.

Delighted volunteer fundraisers Debra and Sian met Alfie after his Cardiff show
Alfie spoke movingly to his army of fans about losing his father, who died in his arms 10 months after diagnosis, inspiring a wave of generosity reaching £20,000
“There is no doubt in my mind that research into brain tumours should be a priority and I am ashamed to think that charities are having to do so much in this area. The Government should be doing so much more
“On a personal level I am also doing this in memory of Dad and I hope that, in sharing my story, it will help other people who are struggling to come to terms with loss and perhaps even bring them some comfort to know they are not alone.”
The nation’s favourite tenor invited our fundraising team to attend his recent 18-date UK tour to collect donations from concert-goers.

Just days after his tour ended in July, Alfie was back out there flying the flag for us. This time, he was launching a special rose in memory of his father at RHS Hampton Court Garden Festival. During the event, Alfie met with Community Fundraiser Emma Jolly who was also just 23 when her father died from a secondary brain tumour.
In the quest to find a cure, for every Alfred Robert Boe rose sold, Harkness Roses, which produces the flamboyant flower, will donate £2.50 to Brain Tumour Research.
Alfie’s unwavering support is set to continue with a planned auction of personal items and more exciting events in the pipeline. Watch this space!
On Thursday 4th July, the UK elected a new Labour Government. This shift in power represented a new chapter in British politics and, significantly, a great opportunity for Brain Tumour Research and our campaigners and activists to come together and use our collective voice to draw attention to the issues that matter to the UK brain tumour community.
New ministerial appointments came thick and fast. Wes Streeting now holds the position of Secretary of State for Health and Peter Kyle is Secretary of State for Science, Innovation and Technology. Sir Patrick Vallance – former Chief Scientific Advisor, physician, scientist and clinical pharmacologist – is the new Science Minister. Brain Tumour Research is engaging with these political stakeholders, and others, to begin conversations about our cause.
Through this period of change, though, our campaigning demands remain constant and the great progress we have made together – the meetings with ministers, the debate in the main chamber, the All-Party Parliamentary Group on Brain Tumours (APPGBT) report and more – will not be lost.
Top image: Wes Streeting attending a Speaker’s House event in 2018 Bottom image: Our manifesto will drive our campaigning asks


One in three know someone affected by a brain tumour

Challenging UK governments and larger cancer charities to invest more in brain tumour research

One of our key priorities is to canvas new MPs for their support of the commitments as set out in our manifesto, It is time to do things differently. We’re calling on the Government to declare brain tumours a clinical priority, enabling research funding into brain tumours to become game-changing across the translational pipeline, and to make six achievable, but impactful, commitments:

• Provide a detailed response to the APPGBT inquiry report, Pathway to a Cure, and an update on the plans to action the recommendations within the report
• The Government to declare brain tumours a clinical priority and to approach improving options and outcomes for brain tumour patients with appropriate urgency
• Double the annual research spend across adult and paediatric brain tumours from the 20/21 total of £17.6 million to £35 million per year by 2028
• Develop a roadmap for full national deployment of the £40 million research funds made available in 2018, in partnership with Brain Tumour Research
• Implement a monitoring system for this spend, with decision-making authority, to be overseen by a new brain tumour research institute – made up of clinicians, researchers and charities – specifically targeted with funding research that will drive both discovery and translational research, so we find cures
• Increased participation of adult and paediatric brain tumour patients in clinical trials
Hugh Adams, our Head of Stakeholder Relations, said: “These priorities will guide our campaigning activity as we engage with parliamentarians with whom we have an established relationship and those who are new to their roles to drive real change for our community. We want to make our agenda, their agenda.
“People cannot support a cause unless they know it exists so we relish this challenge and will seize this opportunity presented by the new Government. The personnel may have changed, but our vision remains the same as we all seek to improve the situation for those diagnosed with a brain tumour and for their families.”
You can help us make sure our combined voice is heard loud and clear by those in power. Sign up to join us as a campaigner on our website: www.braintumourresearch.org/ campaign-with-us
In Scotland, 433 people are diagnosed with a high-grade brain tumour every year
Challenging UK governments and larger cancer charities to invest more in brain tumour research



Our dedicated campaigners advocate for our cause in all four corners of the UK and as the momentum builds at Westminster, we’ve been busy making sure the voice of the brain tumour community is amplified across the devolved nations too.
Scottish support was apparent at our Wear A Hat Day photocall which was attended by all leaders of the main political parties in Scotland and numerous Members of the Scottish Parliament (MSPs). During this event, we emphasised the urgent need for more research into brain tumours to MSPs including the then First Minister Humza Yousaf, who sported our signature pink top hat for the occasion.
The photocall was followed by a reception during which discussions focused on making brain tumours a clinical and strategic priority, improving access to tissue and imaging, and developing the capacity of the Scottish clinical brain tumour research community. Around 60 Scottish supporters heard the personal stories of Beatrice Wishart MSP, whose daughter is living with a brain tumour, and our Patron, Theo Burrell, who was diagnosed with a glioblastoma (GBM) in June 2022. The reception clearly struck a chord with MSPs in attendance. Shadow Health Minister Paul Sweeney said: “Improving the survival of brain tumours must be made a priority now.”

And momentum continues to grow with the establishment of the Cross-Party Group on Brain Tumours in Scotland, with Beatrice Wishart appointed as Convenor. We are extremely proud to announce that Brain Tumour Research will provide the secretariat to the group and look forward to reporting back from future meetings in due course.
In Wales, our Director of Research, Policy and Innovation, Dr Karen Noble, and Thomas Brayford, our Policy and Public Affairs Manager, met with officials in the R&D Division of Welsh Government to discuss our ambitions and opportunities for collaboration with our Welsh research community.

Dr Newland in the lab
We were delighted to be joined by Dr Ben Newland who is leading one such collaborative research project at the Cross-Party Group on Medical Research’s event to showcase research in Wales in July. Dr Newland’s “super sponge” project, which is co-funded by Brain Tumour Research and the Medical Research Council (MRC), represents our first major investment in Wales and will see Dr Newland and colleagues from universities across the UK working to develop an innovative surgically-implanted, drug-delivery system for GBM patients.
There was a great opportunity to speak to Members of the Legislative Assembly (MLAs) about our key priorities in Northern Ireland at the launch of the Northern Ireland Cancer Charities Coalition (NICCC) in Stormont, Belfast. This event represented the start of conversations with elected representatives about ensuring better outcomes for the cancer community and we look forward to continuing these discussions.
To stay up to date with all the latest campaigning and other news from Brain Tumour Research, subscribe to receive our weekly e-news: www.braintumourresearch.org/subscribe
Hugh Adams, our Head of Stakeholder Relations, said: “There is clearly evergrowing support and a desire to do better for brain tumour patients across the devolved governments. We will take every opportunity to continue these important conversations, make sure we are present at key events and work with our committed campaigners across the UK to ensure the voice of the brain tumour community and our call for greater investment in research, which holds the key to new, innovative treatments and ultimately cures, is heard.”
To find out more about or to support one of our Fundraising Groups, visit: www.braintumourresearch.org/ fundraising-groups
AARON’S ARMY
Nicola Wharton, who lost her seven-year-old son to an anaplastic ependymoma in April last year, held a spectacular ball with a villains theme in May this year which raised £2,000 in Aaron’s name. She said: “Aaron loved all things Disney and especially the villain characters. It was his wish to have a villains party.”
The fun-filled evening saw family, parents of Aaron’s friends and even teachers from his primary school come together wearing a whole range of dramatic costumes. Nicola thanked all her guests for “helping to fulfil a little boy’s wish”.

ALBIE AND BEYOND
To mark what should have been the fifth birthday of Albie Bayliss-Watts, his mum Lauren took on the 34km Jurassic Coast Ultra Challenge. She was joined by three Albie and Beyond supporters, while friend Scott braved the full 100km distance from Corfe Castle to Bridport. Their heroic endeavours raised more than £3,200 Lauren said: “Albie was a bright and gorgeous little boy, but my wife Hayley and I lost him aged two to a brain tumour so rare it didn’t even have a name.”
Over the last 15 years, our Fundraising Groups have helped us champion the fight against brain tumours, contributing hundreds of thousands to our cause.





Andi Peel, who died in January 2023 after a three-year battle with a glioblastoma (GBM), was the inspiration for Scarlett and Beth taking on a Summer Wolf Run, conquering obstacles, water and lots of mud. They signed up for the 5k race, but “took a wrong turn and ended up doing the full 10k”. Their courageous exploits raised close to £650
“Wolf Run was absolutely exhausting, but so much fun too” said Scarlett, whose godmother is Linda, Andi’s mum.

Golf Captain at Mid Kent Golf Club for 2024, Ian Greenwood’s support came about through his friendship with Eileen and Mick, the parents of Nick Cotton. His captaincy fundraising stands at more than £11,500, including £3,000 from a golf day in May which saw 20 of Nick’s friends playing among the 117 participants and Nick’s wife Rachael and Eileen and Mick among the guests for the presentations.
Nick was diagnosed with an anaplastic oligodendroglioma just six months after marrying Rachael, his childhood sweetheart. He passed away, aged 30, less than 10 months later.






Joshua’s dad Marc Smart took on the 40-mile Lyke Wake Walk across the North York Moors National Park with his friend Paul over the summer, raising close to £6,000. Joshua passed away in February 2021, aged 18, after diagnosis with a diffuse midline glioma (DMG), also known as DIPG.
Marc said: “Josh’s last physical activity at school was a cross-country run, although he was only well enough to walk it. Walking the North York Moors wasn’t easy, so it felt like there was some connection to Josh.”


Mick Bradley, a husband and father of two, was diagnosed with a glioblastoma (GBM) in September 2022. Despite treatment, he passed away in September 2023.
Mick’s Heroes has been set up by daughters Meg and Amy and Mick’s wife Tracey and, including a Fun Day in June, has raised more than £17,400, thanks in part to sponsorship from the Cygnet Group.


The parents of Taylan Kurtul set up Tay’s Tribe after losing their six-year-old son to an aggressive medulloblastoma in February 2024.


The Hudson family has set up Colours of Hope after losing Dale, a triplet, to an inoperable brain stem glioma in December 2022, aged 31.
Leanne, Dale’s elder sister, said: “We are determined to raise awareness and help fund vital research because, until Dale was diagnosed, we knew nothing about brain tumours.”


TayFest, held in June and offering a range of fun activities for children, raised more than £5,000 to kick off the new Group’s fundraising campaign.

Simon Penwright was diagnosed with a GBM which took his life in November 2023.
Simon’s Drive was established by his wife Emily, and, with support from friends and family, it has already raised around £48,000.

Emily said: “Simon’s Drive will give us a purpose to carry on and help bring hope to other families affected.”
For more information about these Fundraising Groups and how you can donate to their campaigns, go to: www.braintumourresearch.org/ fundraising-groups

We are really pleased to welcome NF2 BioSolutions UK & Europe, The Rudy A Menon Foundation and Yorkshire’s Brain Tumour Charity to our family.

NF2 Biosolutions UK

& Europe is a patient-led charity which works to raise awareness and increase connections, hope and support for NF2-related schwannomatosis-related patients and their families. Its goal is to fundraise for new treatments and ultimately a cure for NF2.
NF2 is a rare genetic disorder affecting approximately 1 in 35,000 people globally, including the husband and children of CEO Clare Goddard, resulting in the growth of multiple tumours throughout the central and peripheral nervous systems.



Originally set up as Andrea’s Gift, this charity was inspired by Yorkshire woman Andrea Key who died from an aggressive brain tumour in May 2002
Today Yorkshire’s Brain Tumour Charity continues to offer vital support to patients and their loved ones through welfare peer support services, welfare advice and financial assistance and oneto-one support and signposting. The charity also invests in local research, with a particular emphasis on seed-funding and innovative projects.


Inspired by Rudy who passed away in 2013 on his 26th birthday from gliomatosis cerebri (GC), The Rudy A Menon Foundation funds research at The Institute of Cancer Research (ICR) into GC and other rare and inoperable brain cancers affecting children and young adults. The charity also provides support and information to families while raising awareness at a global level by engaging with medical and research bodies.

For more information about joining our family of Member Charities email: anju.chadha-mclean@ braintumourresearch.org
Delegates at our summer 2024 Member Charity Workshop
It was lovely to welcome representatives from 12 of our family of 26 charities to a Member Charity Workshop in Milton Keynes recently. And a great opportunity to share updates, demonstrate how we can offer, for example, Fundraising, Marketing or PR support, and for Member Charities to identify how they can help each other and forge closer links.
We enjoyed an enlightening presentation from Vicky Ringer, of Member Charity Levi’s Star, on improving communication between schools and home in order to provide better support to children affected by a brain tumour or neurological condition.
It was a great event and we’re looking forward to the return of these workshops as a regular recurrence.



The Brain & Spine Foundation has set up a Neuro Carers Group to support adults caring for people with neurological conditions, providing a safe space for these carers to socialise with each other and talk openly.
The group meets virtually on the second Tuesday of each month from 10:30am – 11:30am on Zoom.
Neuroscience nurse Jo, a carer herself for her son Jacob, is the group facilitator.



Anna died aged three years and eight months
When Anna’s Hope was set up 18 years ago after Carole and Rob Hughes lost their three-yearold daughter, there was no specialist rehabilitation support for children diagnosed with a brain tumour. Today the pioneering specialist rehab service called Brainbow, which they co-founded at Addenbrooke’s Hospital in Cambridge, is the only service of its kind in the UK and now helps more than 200 children and their families each year.
Anna’s Hope is now funding a Speciality Lead for Brainbow with the aim of leading and further developing this service.





Tristan Cork set up Finnbar’s Force, a Norfolkbased charity, after losing his son Finnbar aged five from a diffuse astrocytoma in 2016. He and volunteer Sophie Cooke-Shaw organised the first Little Fox Ball, which raised an incredible £13,000, to help support families with children who’ve had a cancer diagnosis, as well as research projects specialising in paediatric brain tumours. Finnbar’s Force has also recently opened a new support hub called The Den in Norwich for families affected by childhood cancer.


One of our newest Member Charities, Yorkshire’s Brain Tumour Charity (YBTC) has an exciting programme of peer support walks across the whole of Yorkshire for families affected by brain tumours. These allow participants to engage with each other in beautiful settings that are wheelchair friendly and accessible to all, finishing with a cuppa and a slice of cake. Regular walker, Heather said: “We have all become good friends too and share experiences outside the walks. It’s a very positive and healthy way to enhance the life of brain tumour patients and their family and friends.”
Harbour Learning Trust, a multiacademy trust in Grimsby, is helping to create videos to promote the James Clifford Campling Trust, set up by Diane Campling after she lost her son James, aged 29, from a glioblastoma (GBM). CEO Richard Briggs said: “It’s particularly poignant because lots of people in the local community remember James and all of his adventures, particularly if they attended Healing Academy. We know that he would be overjoyed by the support and continuation of his legacy within Healing.”



To learn more about the potential benefits of collaborating with Brain Tumour Research as a Member Charity, please email: anju.chadha-mclean@ braintumourresearch.org
After losing her husband Steve to a brain tumour, Jane Dixon set up a regular donation to Brain Tumour Research to make a different in his memory. The first sign that anything was wrong with Steve was when he noticed tingling, numbness and a lack of co-ordination in his left hand. He went to the doctor and was told he might have had a stroke. A CT scan revealed a mass on his brain which was later confirmed to be a glioblastoma (GBM).
Four days after his diagnosis in March 2019, Steve underwent surgery to debulk the tumour. This was followed by radiotherapy and chemotherapy.
Five months later, Steve and Jane married. It was a beautiful hot summer’s day which they were able to share with their loved ones. Jane said: “It was such a wonderful occasion and I’m so glad we did it before Steve became ill again.”



When a routine scan revealed tumour progression, Steve had a second surgery and more chemotherapy, but sadly it didn’t work. He passed away at home on 9th January 2021, aged 59, with Jane by his side.


Steve and Jane on their wedding day
Since losing Steve, Jane has fundraised for Brain Tumour Research and asked for donations to the Charity at Steve’s funeral. Jane has also held an annual raffle since 2020, raising more than £500 each year. She said: “Steve took his diagnosis and treatment with great courage and never once complained. He was such a caring , loving husband, father, brother and grandad. I have also set up a direct debit to make a regular donation to help this worthy cause. Through my own tragic experience, I became all too aware of the terrible statistics surrounding brain tumours and the lack of options for patients like Steve. I want to do all I can to help ensure other families are not torn apart by this terrible disease.”
are indiscriminate; they can affect anyone at any age


With each day of research costing £2,740 a regular donation can make a real difference and we’re grateful to all those who support us with a regular gift. This is a wonderful way to support our fight to find a cure. Here’s how your gift could help:
£5 a month could pay for all essential lab dishes and microplates our researchers need, used every day by the teams for many different experiments, including measuring the success of different drugs in attacking brain tumour cells.

£10 a month could buy a regular supply of vital tissue culture media, essential for growing brain tumour cells so our researchers can carry out their key experiments to discover new treatments.
£25 a month could help sustain ground-breaking investigations by a senior researcher at one of our dedicated Centres of Excellence, testing promising results further that could potentially lead to new clinical trials for patients where other treatments have failed.
£50 a month could allow a Senior Research Fellow to publish a paper, helping put more pieces of the jigsaw in place for ways to treat and destroy brain tumours, bringing new hope for a brighter future for everyone affected by this devastating disease.
To find out more and set up a regular donation, or to make a one-off donation, visit: www.braintumourresearch.org/donate
Specialist lab equipment regularly used by research teams in our Centres of Excellence to continue to fund life-saving research

Silvia Marino, Queen Mary University London and her article published in Nature Communications in 2021

Christmas will be here soon and we’ve got everything you need to prepare for the festive season.
Send your loved ones a special message with our charity Christmas cards and with every message you write, you’ll be helping us get closer to finding a cure for brain tumours.
Available in a range of designs, cards come in packs of 10 and cost £4.50 per pack.
We’ve also got a great collection of gift wrap and tags so your presents look extra special under the tree, and you’ll find even more festive merchandise on our website.






















COULD YOU SELL A BOX OF CARDS ON OUR BEHALF?
As well as buying our cards to write your own messages, we can supply boxes of mixed cards on a sale-or-return basis for you to sell to family, friends, colleagues, neighbours, at Christmas stalls, fetes, markets, and in your school, club, church or workplace to help maximise the money you raise this winter.







Order your box by calling our head office on: 01908 867200


Christine Abbott
Martin John Andrew
David Austin
Mike Avis
Martin Bagg
Terence Bailey
Nicky Kaur Bains
Jen Bamber
Henry Barringer
Stuart Bateman
Amy Bell
David Bentley
Adrian David
Bicker-Caarten
Christopher Blow
Carolyn Bourne
Janet Braker
Steven Brammer
Carla Brennan
Kevin Brennan
Joanne Brookes
Martin Buck
Ian Buckingham
Graham Burdge
Evie Carey
Michael Vincent Carter
John Charvet
Michael Clough
Edith Gertrude Collins
Margaret Ann Connolly
Martin Cooke
Pat Cooke
Edward Curry
Trevor Cutler
Betty Darbon
Mark Davies
Martin John Davies
Norma Joyce Davies
Chavier de Abreu
Kate Deakin
Patricia Driver
Jessie Elliott
Keith Elliott
Steve Ellis
Wayne Elvin
Mark Endersby
Sheila Agnes Evans
Barry Fair
From all of us at Brain Tumour Research, our love and thoughts are with all those who inspire us and with everyone who continues to support us in memory of their loved ones and colleagues, year after year.
Christopher-John Ferrina
Helen Flynn
Michael Ford
Alison Fraser
Jasmine-Lily Freeman
Richard Furniss
Terry Garland
Caroline Gerrard
Lee Gibson
Karen Giles
David Glaister
Stanley George Godden
Daniel Godfrey
Margaret Godfrey
Linda Goode
Catherine Goodwin
Christine Greasley
Lorraine Green
Duncan Hambidge
Kevin David Hampton
Stephen Harrison
Stuart Harrison
Dave Hawkins
Linda Mary Haynes
Martin Heaney
William Henderson
Pauline Herron
Andrew Hibberd
Neil Hipkiss
Peter Hipwell
Charlotte Hobbs
Elva Holgate
Lee Hopkinson
Annette Huggett
Steven Hunt
Valerie Allen Gibson
Hunter
Stephen Husband
Derek Isaacs
Stephen Jackson
Joan ‘Audrey’ Jenkins
Michael Edward Jenkins
Thayaa Ji
Joe Johal
Narinder Johal
Andy Jones
Lee Kirkman
Jill Kudlacek

We thought of you with love today, but that is nothing new. We thought about you yesterday, and days before that too. You are forever in our hearts.
Anthony Law
Steven Legg
Doreen Lewis
Eva Winifred Lewis
Brenda Liberman
Tim Longton
Catrin Macey
Peter John Mathews
Duncan McCall
Diane McDonald
Murdoch McGuire
John McMahon
Brian Mead
Francis Terence Mercer
John Robert Micklethwaite
John Mizen
James Montague
Robat Morgan
Joanna Morgan-Jones
Balvinder Kaur Mudan
Christine Mullett
Janet Noyce
Graham Roy Nugent
Eileen O’Brien
Kevin O’Brien
Richard O’Callaghan
Stephen Overton
Paul Randall Paris
Chris Parker
Michael Patey
Linda Peacock
Jeremy Penfold
Simon Penwright
Gloria Picken
Michael Poland
Vince Power
John Rainbow
Julie Reid
Kathleen Reid
Jozef Riba
John Richardson
Ian Riddell
Fred Roberts
Pauline Robinson
Pat Sage
Jacqueline Sampson
David Satchell
Doreen Scott
Surjit Sekhon
Shiva Shahriari
Areesha Shalton-Evans
Margaret Miriam Sherwin
Colin Short
Lorna Short
Geoffrey Smith
Jennifer Smith
Lizzi Snaith
Jacqueline Angela
Stevens
Keith Steward
Robert Stillman
Milan Svoboda
Janet Sykes
June Tate
Jamie Teagle
Owen Thomas
Mark Tomalin
Sarah Tonge
Peter John Turner
Jessie Verth
Phil Wake
Andrew Wallace
Reverend
Brian John Wallis
Christopher Waring
David Wilfred Warner
Peter Webster
James White
Jacob Whitehead
Graham Whiteley
Christine Wilcock
Jim Wiley
Adrian Wilkin
Daniel Wilkinson
Richard Charles Woodrow
Emily Louise Yates
Loved ones here include those lost to a brain tumour for whom we received funeral donations between January and June 2024.








































